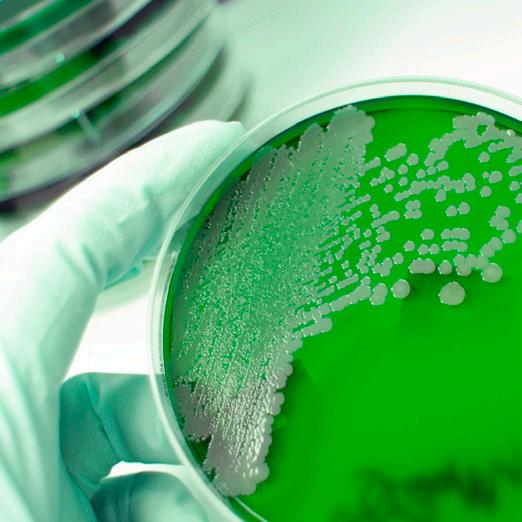

N AC
OXIDATION
CHEMISTRY
N AC
OXIDATION
CHEMISTRY
1 AFRENSER TIL ORGANISK FORURENING
IN ONE 3 2
PLETFJERNER / BLEGEMIDDEL
LUGTFJERNER
N AC
OXIDATION CHEMISTRY
N AC
OXIDATION CHEMISTRY
![]()
N AC
OXIDATION
CHEMISTRY
N AC
OXIDATION
CHEMISTRY
1 AFRENSER TIL ORGANISK FORURENING
IN ONE 3 2
PLETFJERNER / BLEGEMIDDEL
LUGTFJERNER
N AC
OXIDATION CHEMISTRY
N AC
OXIDATION CHEMISTRY
Serum 1000 – til afrensning af skimmelsvamp og anden svær biologisk/organisk forurening.
N AC
OXIDATION CHEMISTRY
N AC
OXIDATION CHEMISTRY
Serum 1000 reducerer besværligt manuelt arbejde, afslutter projekter hurtigere og nedbringer generelt omkostninger i forbindelse med afrensning og sanering af skimmelsvamp.






OXIDATIONS- OG RENGØRINGSSYSTEM
MINI SPRAYER
Accelereret
oxygenbaseret soft spray system

2 1 AFRENSER TIL ORGANISK FORURENING
IN ONE 3
PLETFJERNER / BLEGEMIDDEL
LUGTFJERNER

Serum Accelerator
Indhold: 443 ml
Varenr. 5-215DT-06

5 liter plastbeholder, transparent med bærerem, som letter arbejdet.
Rengøring efter vand- og kloakskader m.v. i private hjem og virksomheder skal tages alvorligt.
Serum 1000 sprøjten sikrer dig et 100% perfekt resultat hver gang!
En sprøjte kun til Serum 1000 sikrer, at brugeren ikke blander andre kemikalier i sprøjten.
Fås også i 1,25 liter.
Serum Sprøjte
Indhold: 1,25 liter
Varenr. 51-6150000-S
Serum 1000
Indhold: 19 liter
Varenr. 5-215DT-05
Serum Sprøjte
Indhold: 5 liter
Varenr. 51-6200000-S






Kraftigt rengøringsmiddel/oxidationsmiddel til fjernelse af svær organisk/ biologisk forurening f.eks. skimmelsvamp i huse og bygninger.
SERUM 1000 er et specialformuleret produkt, baseret på Hydrogenperoxid (H2O2) der bl.a. indeholder overfladeaktive stoffer (tensider), som nedsætter overfladespændingen dramatisk og dermed effektivt øger Serums befugtningsevne. Ved at nedsætte overfladespændingen, er Serum i stand til, via kapillar virkning, at trænge ind i revner og sprækker, samt dybt ind i træ og andre porøse materialer.
SERUM 1000 reagerer med skimmelsvamp (katalase-enzymer) og genererer og frigiver store mængder oxygen. Denne kemiske reaktion danner meget kraftigt skum, som koger op og bringer organisk snavs (skimmelsvamp) og anden forurening op til overfladen fra porøse materialer, således at det senere kan fjernes. Denne reaktion sker også med pletter og misfarvninger på trækonstruktioner, gipsplader m.v. og vil lysne/blege materialets udseende.
SERUM 1000 bringer alle urenheder op til overfladen, således at de kan fjernes vha. en Hepa støvsuger. Efter Hepa-støvsugningen, fremtræder overfladerne rene, lyse, fri for skimmelsvamp og anden organisk forurening.
Den bedste metode til påføring af SERUM 1000 er vha. airless sprøjteteknik. Med denne påføringsmetode opnår man maksimal dækning på mindst mulig tid og sparer arbejdstid sammenlignet med andre metoder til fjernelse af skimmelsvamp. SERUM 1000 genererer og/eller efterlader ingen sundhedsskadelige kemikalier, beskadiger ikke overflader, som tåler vand og frigiver ingen giftige/sundhedsskadelige dampe.
• Hydrogenperoxidbaseret (H2O2) teknologi/kemi.
• Fjerner al organisk forurening fra overflader.
• Oxiderer og eliminerer lugt.
• Fjerner pletter og bleger/lysner trækonstruktioner.
• Klorfri.
• Uskadelig for alle vandresistente overflader.
• Biologisk nedbrydelig.
• Serum nedbrydes til vand og oxygen (O2).
• Skummer kraftigt ved kontakt med organisk materiale (bl.a. katalase-enzymer).
• Får organisk materiale til at "koge op" på overfladen.
SERUM 1000 reagerer med skimmelsvampen og genererer, samt frigiver store mængder oxygen. Denne kemiske reaktion producerer meget kraftigt skum, som koger op og bringer organisk forurening op til overfladen fra porøse materialer. Serum 1000 fjerner også pletter og misfarvninger på trækonstruktioner, gipsplader m.v. og vil lysne/blege materialets udseende.
SERUM 1000 bringer alle urenheder op til overfladen, således at de kan fjernes vha. en Hepa støvsuger. Efter Hepa-støvsugningen, fremtræder overfladerne rene, lyse, fri for skimmelsvamp og anden organisk forurening.
Organisk forurening
Lugt
Pletter
Over ade
Serum 1000 renser og oxiderer organiske sto er fra over aden og koger forureningen op i skummet. Pletter og lugt ernes fra over aden i samme proces. 1
2
Herefter ernes den organiske forurening fra over aden med HEPA støvsuger.
Kraftigt rengøringsmiddel/oxidationsmiddel til fjernelse af svær organisk/ biologisk forurening f.eks. skimmelsvamp i huse og bygninger.
BRUGSVEJLEDNING
Læs den for opgaven relevante procedure, før produktet tages i brug. Bær relevante personlige værnemidler, når der arbejdes med produktet. Sprøjt en generøs mængde SERUM 1000 på det område, der skal rengøres. Lad sidde et par minutter, inden du fortsætter. Afhængig af forureningsgrad, bearbejdes overfladen med en børste for at sikre den nødvendige penetrering af væsken. Lad igen SERUM 1000 sidde et par minutter for at virke. Når farven på pletten fortoner sig, påføres SERUM 1000 igen. Efterhånden som produktet virker, frigøres oxygen og produktet bliver mindre effektivt. Fornyet påføring hjælper med at genskabe blege- og rengøringseffekten. Efter rengøringen, støvsuges overfladerne med HEPA støvsuger. Ved støvsugningen fjernes al forurening, som er kogt op fra overfladen.
IKKE BENYTTET VÆSKE MÅ IKKE RETURNERES TIL DEN ORIGINALE BEHOLDER.
DÆKKEEVNE
På porøse overflader 7-8 m2. pr. liter, afhængig af forureningsgrad og porøsitet. På ikke-porøse overflader er dækkevenen højere.
Serum anvendes koncentreret. PH-værdi koncentrat: 3,5.
FORHOLDSREGLER
Undgå hudkontakt. Må ikke indtages. Opbevares utilgængeligt for børn. Når produktet ikke er i brug skal beholderen holdes tæt lukket. Opbevar beholderne i kølige, tørre områder. Opbevares ved temperaturer under 38°C. Undgå udslip til kloak og vandløb. Genbrug ikke den tomme beholder. Ubenyttet materiale må ikke fyldes tilbage til den originale beholder. Personlige værnemidler: anvend fuld ansigtsskærm med filter, fuld beskyttelsesdragt med afdækning af hoved og fødder, kemikalieresistente handsker og støvler, dragt og handsker tapes fast ved håndleddet for at undgå utilsigtet eksponering med produktet. Udskift filtre iht. producentens anbefalinger. Beskyttelsesdragten kasseres efter brug. GENBRUG IKKE BESKYTTELSESDRAGTEN. Vi henviser i øvrigt til produktets fareidentifikation, samt sikkerhedsdatabladet for Serum 1000.
FORSENDELSESINSTRUKTION
HYDROGEN PEROXID, VANDIG OPLØSNING (med min. 8% men max. 20% hydrogen peroxid, 5.1, UN-2984, PG III.

Serum 1000 – ikke kun til skimmel
Serum 1000 blev specialdesignet til effektiv afrensning og oxidation af skimmelsvamp, men på grund af de unikke produktegenskaber kan Serum 1000 med stor succes indsættes ved andre svære rengøringsopgaver, hvor Serum 1000 på suveræn vis vil rense og oxidere organisk forurening og samtidig eliminere alle lugtgener.
Eksempler:
- Svær biologisk forurening ved kloakskader o.lign.
- Svær biologisk forurening ved ligfund m.v. (ligvæsker).
- Rengøring på gerningssteder f.eks. blod.
- Lugtskader – Serum 1000 oxiderer permanent restlugt fra røg- og sodskader.
- Lugtskader efter katteurin m.v.
- Generel afrensning og oxidation af svær biologisk/organisk forurening.




Serum´s Mini Soft Sprøjte vil automatisk blande Serum 1000 korrekt med Serum 1000 Accelerator for at skabe milliarder af hydroxylradikaler, som angriber og nedbryder de enzymer/biofilm som forårsager skimmelpletter.
SERUM ELIMINATOR MINI SYSTEM
HAR MANGE ANVENDELSER:
• Fjernelse af pletter og misfarvninger efter skimmelsvamp.
• Alle kloakskader.
• Ligsanering.
• Rengøring af kælder og loft.
• Rengøring af krybekælder og -loft.
• Rengøring af undertag.
• Oprydning af bygningsfacader.
• Lugtfjernelse efter brandskade.
• Rengøring af skimmeltramt træværk.
• Rengøring af statuer og monumenter.
• Rengøring af gernings- og ulykkessteder.
• Eller enhver anden fjernelse af organisk materiale.
• Hydrogenperoxidbaseret (H2O2) teknologi/kemi
• Fjerner al organisk forurening fra overflader
• Oxiderer og eliminerer lugt
• Fjerner pletter og bleger/lysner træværk
• Uskadelig for alle overflader der tåler vand
• Bio-nedbrydeligt
• Klorfri. Nedbrydes til vand og ilt
• Skummer kraftigt ved kontakt med organisk materiale (katalase-enzym)
• Får organisk materiale til at koge op til overfladen
• Kemisk sprøjtedækning 28 m2 per gallon (3,8 L)
• Letvægt og nem at transportere
Det nye Eliminator MINI Soft Wash System fra Serum. Denne helt nye fuldautomatiske sprøjte er det bedste værktøj, der er blevet udviklet til skadeservice- og miljøsaneringsbranchen i årevis. Brug Serum 1000 og Accelerator med denne maskine og du vil se FANTASTISKE resultater inden for få minutter.
Eliminator Spray System fra Serum System er et vandløst, lavtryks, lav volumen, soft-wash-system til rengøring og blegning af skimmelangreb. I modsætning til standard airless sprøjtesystemer, muliggør Eliminator fuld kontrol over en normalt ukontrollabel kemisk reaktion, for i høj grad at forbedre rengøringsresultaterne uden spild af produkt.
Konceptet efterlader optisk flotte resultater, som påskønnes af skadelidte, skimmelsaneringsteknikere og forsikringsselskaber.

De FIRE eneste årsager til at mikrobielle prøveudtagninger (eksempelvis Mycometer, aftryksplader, BioDetect) ikke godkendes ved arbejde med Serum 1000 er:
1. MANGLENDE TØRRING/AFFUGTNING.
Hvis fugtindholdet i materialerne/overfladen ligger meget højere end 15% relativ luftfugtighed, vil Serum 1000 ikke kunne penetrere ned i overfladen og få kontakt med svamperødder (Hyfer). Der vil hermed opstå en mulighed for genvækst.
2. UTILSTRÆKKELIG HEPA-STØVSUGNING.
Hver cm2 skal støvsuges med en effektiv børste.
3. UTILSTRÆKKELIG INDDÆMNING AF SKADESTEDET.
Ved skimmelsvampsanering er det vigtigt at afskærme arbejdsområdet, for at undgå unødvendig kontaminering af allerede rengjorte overflader.
4. PÅFØRINGSPROCEDURE IKKE FULGT.
Det vil i mange tilfælde betyde, at man ikke har gentaget påføringen af Serum 1000 på de områder, der skummede. Én misforståelse omkring Serum 1000 er, at "mere er bedre". Man påfører Serum 1000 meget generøst én gang og fortsætter herefter. Problemet er, at uanset om man bruger lidt eller meget, vil produktet omdannes til vand og ilt i løbet af 20 minutter. Det er derfor, vi i vores procedure foreskriver flere lag. Man skal OGSÅ behandle HVER eneste cm2 i inddæmmede områder (hvilket muligvis heller ikke sker) og derefter igen sprøjte de områder, der skummede.




Sådan anvendes Serum 1000 i forbindelse med skimmelsvampsanering.
For at sikre et korrekt udført arbejde, er det vigtigt at følge denne enkle påføringsprocedure:
1. Inddæm arbejdsområdet (eksempelvis opsætning af Zipwall).
2. Foretag test på angrebne områder.
3. Lad overfladen tørre ned til under 15% fugtindhold.
4. Fej og støvsug området med industristøvsuger for at fjerne byggeaffald m.v. (HEPA STØVSUGNING ER IKKE NØDVENDIG).
5. Påfør Serum 1000 på ALLE overflader i det inddæmmede område.
6. Skrub områder med kraftig skumdannelse, kraftig misfarvning/pletter eller svær skimmelvækst, derefter påføres Serum 1000 påny.
7. Vent MINDST 20 minutter og påfør derefter igen Serum 1000 på de områder, der skummede under trin 5 (gentag til det ikke længere skummer).
8. Når alle områder er holdt op med at skumme, ventes indtil overfladerne er tørre. Opsæt evt. affugter for at fremskynde tørringen af området.
9. Når området er tørt, HEPA støvsuges HVER cm2 meget grundigt inden for det inddæmmede område.
10. Påfør evt. Serum 2000, Concrobium eller et produkt fra Fosters.
11. Tænd for HEPA-luftrenserne og udfør mikrobielle prøveudtagninger.
Følges denne procedure, kan enhver bolig eller krybekælder saneres fra dag til dag af blot to teknikere.
BESKRIVELSE
Serum 1000 Accelerator er et specielt formuleret additiv, som markant fremskynder Serum 1000’s evne til at afrense og blege. Serum 1000 har i mange år ydet en fejlfri indsats ved afrensning/blegning af skimmel og anden svær biologisk/organisk forurening. Serum 1000 Accelerator er formuleret til at få Serum 1000 til at genere millioner af hydroxylradikaler, der fremmer den afrensende og blegende effekt specielt på genstridige sorte skimmelpletter. Med den super effektive Serum 1000 Accelerator kan man nu ekstremt hurtigt fjerne skimmelsvamp/organisk forurening og samtidig være sikker på, at al misfarvning og pletter forsvinder, hvilket resulterer i optisk flotte og skimmelfrie overflader. Den aktiverede Serum 1000 har en pH-værdi på 9 (Serum 1000 har en pH-værdi på 3,2). De eneste biprodukter af Serum 1000 Accelerator er vand, oxygen og kaliumacetat (et fødevaretilsætningsstof).
BRUGSANVISNING - 5 LITER SERUM 1000 TRYKSPRØJTE
Hæld IKKE mere end 1-2 liter Serum 1000 i Serumsprøjten. Ved 1 liter tilsættes 25 ml Accelerator. Ved 2 liter tilsættes 50 ml Accelerator. Tilsæt først Acceleratoren til Serum 1000, når du er klar til at afrense. Skru pumpen i omgående. Ryst ikke sprøjten.
Påbegynd straks behandlingen og brug blandingen inden for 15 min.
GENERELT FOR ALLE PÅFØRINGSMETODER
Sprøjt den aktiverede Serum 1000 på alle kontaminerede overflader som normalt. Bearbejd områder med kraftig, synlig skimmel eller kraftige mørke pletter med en stiv børste, mens blandingen sprøjtes på disse områder. Du vil se kraftig skumdannelse fra overflader med levende organismer. Sprøjt på de skummende områder igen efter 10 minutter. Dannes der intet skum, er området renset. Skummer det stadig, påføres den aktiverede Serum 1000 blanding endnu engang, indtil skumningen stopper. Vent mindst 1 time til overfladerne er tørre og HEPA støvsug alle overflader i det kontaminerede område grundigt.
1 Flaske Serum 1000 Accelerator (443 ml) rækker til 1 dunk Serum 1000 (19 liter). Hvis der skal anvendes mindre end 19 liter, bruges 25 ml Accelerator pr. liter Serum 1000. Det er vigtigt ikke at overskride doseringen, da Serum 1000 ellers vil skumme ekstremt kraftigt. Brug derfor kun 25 ml Accelerator pr. liter Serum 1000.
VIGTIGT!
Hvis der efter endt brug befinder sig en rest af aktiveret Serum 1000 i beholderen, så undlad at skrue låget helt fast således at den ilt som opstår ved at aktivere Serum 1000 med Accelratoren kan ventileres gennem skruelåget. Tilføjes mere Accelerator end foreskrevet, vil opløsningen overreagere og begynde at skumme ud af beholderen. Hvis dette sker i en lukket beholder, som f.eks. en pumpesprøjte, fjernes pumpen straks fra beholderen, så trykket ikke opbygges til det punkt, hvor beholderen lider overlast. Indeholder kaliumhydroxid. Brug kemikaliebestandige handsker og øjenbeskyttelse ved håndtering og ophældning af dette produkt.

Serum Accelerator
Indhold: 443 ml
Varenr. 5-215DT-06




PICTURES OF WOOD UNTREATED AND TREATED WITH SERUM 1000 ACCELERATED
BEFORE - ORIGINAL PALLET NO. 1
PICTURES OF WOOD UNTREATED AND TREATED WITH SERUM 1000 ACCELERATED
BEFORE - ORIGINAL PALLET NO. 1

PALLET NO. 1 AFTER TREATING THE BOTTOM HALF WITH ACCELERATED SERUM 1000
PALLET NO. 1 AFTER TREATING THE BOTTOM HALF WITH ACCELERATED SERUM 1000

Efter behandling af den nederste halvdel med accelereret SERUM 1000


















Utgivningsdatum: 18-06-2012
Version: 01.00/SWE
AVSNITT 1: Namnet på ämnet/blandningen och bolaget/företaget
1.1 Produktbeteckning
Handelsnamn: Serum 1000
1.2 Relevanta identifierade användningar av ämnet eller blandningen och användningar som det avråds från
Rekommenderad användning: Kraftigt rengöringsmedel avsett för organiska eller biologiska föroreningar. Exempel på användningsonråden: Mögelskador i hus och konstruktioner, sanering efter kloakskador, sent upptäckta dödsfall, katturin, m.m.
1.3 Närmare upplysningar om den som tillhandahåller säkerhetsdatablad
Distributör: NAC europe ApS Ellegårdvej 18 6400 Sønderborg Danmark
Tel: +45 74 42 62 92
Fax: +45 74 42 47 86
E-post: info@nac-europe.com
1.4 Telefonnummer för nödsituationer 112 - begär Giftinformation
AVSNITT 2: Farliga egenskaper
2.1 Klassificering av ämnet eller blandningen
DPD-klassificering: Xn;R22 Xi;R41
CLP-klassificering: Eye Dam. 1;H318 Acute tox. 4; H302
Se avsnitt 16 för kompletta texter i R- och H-fraser
Allvarligaste skadliga effekterna:Orsakar allvarliga ögonskador. Skadligt vid förtäring.
2.2 Märkningsuppgifter


Signalord: Fara
Innehåller Väteperoxid 10-25 %
H-fraser: Orsakar allvarliga ögonskador. Skadligt vid förtäring.
P-fraser: Använd ögonskydd/ansiktsskydd. VID KONTAKT MED ÖGONEN: Skölj försiktigt med vatten i flera minuter. Ta ur eventuella kontaktlinser om det går lätt. Fortsätt att skölja. Kontakta genast GIFTINFORMATIONSCENTRAL eller läkare.
2.3 Andra faror
Bedömning för att avgöra PBT och vPvB har inte utförts.
AVSNITT 3: Sammansättning/information om beståndsdelar
3.2 Blandningar
Registreringsnummer CAS/ EG-nr Ämne
7722-84-1
231-765-0
64-19-7
200-580-7
Väteperoxid
Ättiksyra, mer än 10 procent i vikt
Se avsnitt 16 för kompletta texter i R- och H-fraser
DSD-klassificering/ CLP-klassificering
R5 O;R8 Xn;R20/22 C;R35 Ox. Liq. 1;H271 Acute Tox. 4;H332 Acute Tox. 4;H302 Skin Corr. 1A;H314
R10 C;R35 Flam. Liq. 3;H226 Skin Corr. 1A;H314
Övrig information: Enligt förordning (EG) nr 648/2004 om tvätt- och rengöringsmedel. mindre än 5% nonjoniska tensider 15% och däröver, men mindre än 30% syrebaserade blekmedel
AVSNITT 4: Åtgärder vid första hjälpen
4.1 Beskrivning av åtgärder vid första hjälpen
Inandning: Sök frisk luft. Sök läkare i händelse av bestående obehag.
Förtäring:
Skölj munnen noga och drick 1-2 glas vatten i små klunkar. Sök läkare i händelse av bestående obehag.
Hud: Avlägsna förorenade plagg. Tvätta huden med vatten. Sök läkare i händelse av bestående obehag.
Ögon: Spola omedelbart med mjuk vattenstråle eller ögonspolvätska minst 15 minuter. Ta bort eventuella kontaktlinser. Håll ögonlocken vitt uppspärrade under spolningen så att inget fastnar under dem. Sök läkare efter den initiala spolningen. Fortsätt skölja tills medicinsk personal tar över.
Övrig information: Vid kontakt med läkare, visa säkerhetsdatablad eller etikett.
4.2 De viktigaste symptomen och effekterna, både akuta och fördröjda Farligt vid förtäring. Kontakt med ögonen kan orsaka svåra frätskador, smärta, tårbildning och kramper i ögonlock. Risk för allvarliga ögonskador/synskador. Kan vara hudirriterande - kan orsaka rodnad. Inandning av spraydimma kan orsaka irritation i de övre luftvägarna.
4.3 Angivande av omedelbar medicinsk behandling och särskild behandling som eventuellt krävs Kräver ingen speciell, omgående behandling.
AVSNITT 5: Brandbekämpningsåtgärder
5.1 Släckmedel
Lämpliga släckmedel Släck med pulver, skum, koldioxid eller vattendimma. Använd vatten eller vattendimma för att kyla ej antänt material.
Olämpliga släckmedel Spruta inte vatten eftersom detta kan sprida branden
5.2 Särskilda faror som ämnet eller blandningen kan medföra Produkten är inte antändlig vid direkt inverkan av låga. Undvik att inandas ångor och gaser –andas in frisk luft.
5.3 Råd till brandbekämpningspersonal Avlägsna behållare från det farliga området om så kan ske utan risk. Undvik inandning av ångor och rökgaser – sök frisk luft. Om det föreligger risk att exponeras för ånga och rökgas ska sluten andningsapparat användas.
AVSNITT 6: Åtgärder vid oavsiktliga utsläpp
6.1 Personliga skyddsåtgärder, skyddsutrustning och åtgärder vid nödsituationer
För annan personal än räddningspersonal: Stå i motvind/håll avstånd till källan. Använd handskar. Bär skyddsglasögon/ansiktsskydd. Använd andningsskydd vid otillräcklig ventilation.
För räddningspersonal: Utöver ovanstående: Skyddsutrustning som uppfyller EN 368, typ 3 rekommenderas.
6.2 Miljöskyddsåtgärder
Undvik att låta spill nå avlopp och/eller ytvatten.
6.3 Metoder och material för inneslutning och sanering
Avgränsa och absorbera spill med sand eller annat absorberande material. Placera i lämplig avfallsbehållare. Torka upp mindre spill med en trasa.
6.4 Hänvisning till andra avsnitt
AVSNITT 7: Hantering och lagring
Se avsnitt 8 för typ av skyddsutrustning. Se avsnitt 13 för ytterligare information.
7.1 Försiktighetsmått för säker hantering
Arbeta med effektiv processventilation (t.ex. punktutsug). Rinnande vatten och ögondusch måste finnas tillgängligt. Tvätta händerna före raster, före toalettbesök och efter avslutat arbete.
7.2 Förhållanden för säker lagring, inklusive eventuell oförenlighet Förvaras säkert, oåtkomligt för barn och avskilt från livsmedel, djurfoder, mediciner etc. Förvaras frostfritt. Förvaras vid temperatur under 50°C.
7.3 Specifik slutanvändning Inga.
AVSNITT 8: Begränsning av exponeringen/personligt skydd
8.1 Kontrollparametrar
Gränsvärden för yrkesmässig exponering:
Ingrediens: Exponeringsbegränsning Anm. Väteperoxid
NGV: 1, TGV: 2, KTV: - ppm
NGV: 1,4, TGV: 3, KTV: - mg/m3-
NGV: Nivågränsvärde, TGV: Takgränsvärde, KTV: Korttidsvärde. Rättslig grund: Hygieniska gränsvärden - AFS 2011:18
Mätmetoder: Förenlighet med angivna gränsvärden för yrkesmässig exponering kan kontrolleras genom yrkeshygieniska mätningar.
8.2 Begränsning av exponeringen
Lämpliga tekniska kontrollåtgärder:Den personliga skyddsutrustning som anges nedan ska användas. Se även avsnitt 7.1.
Personlig skyddsutrustning, skyddsglasögon/ansiktsskydd: Bär skyddsglasögon/ansiktsskydd. Skyddsglasögon ska uppfylla EN 166.
Personlig skyddsutrustning, hudskydd:
Personlig skyddsutrustning, andningsskydd:
Använd handskar. Typ av material och tjocklek: Nitrilgummi. Penetreringstiden har inte fastställts för produkten. Byt handskar ofta. Handskar ska uppfylla EN 374.
Använd andningsskydd vid otillräcklig ventilation. Filtertyp: B. Vid spoling/bildning av spolånga: Filtertyp: B. Andningsskydd ska uppfylla en av följande standarder: EN 136/140/145.
Begränsning av miljöexponeringen:Säkerställ att lokala bestämmelser för utsläpp efterlevs.
AVSNITT 9: Fysikaliska och kemiska egenskaper
9.1 Information om grundläggande fysikaliska och kemiska egenskaper
Tillstånd: Vätska
Färg: Klar
Lukt: Data saknas
Lukttröskel: Data saknas
pH (brukslösning): Ca. 4,5 (1%)
pH (koncentrerad): Ca. 3,5
Smältpunkt/fryspunkt: -14°C
Initial kokpunkt och kokpunktsintervall: 218°C
Flampunkt: Data saknas
Avdunstningshastighet: Data saknas
Brandfarlighet (fast form, gas):Data saknas
Övre/undre brännbarhetsgräns:Data saknas
Övre/undre explosionsgräns:Data saknas
Ångtryck: Data saknas
Ångdensitet: Data saknas
Relativ densitet: 1,05 g/cm3
Löslighet: Blandbar med vand Fördelningskoefficient n-oktanol/vatten: Data saknas
Självantändningstemperatur:Data saknas
Sönderfallstemperatur: Data saknas
Viskositet: Data saknas
Explosiva egenskaper: Data saknas
Oxiderande egenskaper: Data saknas
9.2 Annan information
Halt av torrsubstans: 18,2%
AVSNITT 10: Stabilitet och reaktivitet
10.1 Reaktivitet
10.2 Kemisk stabilitet
10.3 Risken för farliga reaktioner
Produkten är oxiderande.
Produkten är stabil förutsatt att den används i enlighet med leverantörens anvisningar.
Produkten är inte lättantändlig men kan mata en brand på samma sätt som syrgas.
10.4 Förhållanden som ska undvikas
10.5 Oförenliga material
Undvik uppvärmning och kontakt med antändningskällor. Undvik direkt solljus.
Inga kända.
10.6 Farliga sönderdelningsprodukter Inga kända.
AVSNITT 11: Toxikologisk information
11.1 Information om de toxikologiska effekterna
Akut oral toxicitet: Farligt vid förtäring. Testdata finns ej tillgängligt.
Akut dermal toxicitet:
Akut inhalationstoxicitet:
Produkten behöver inte klassificeras. Testdata finns ej tillgängligt.
Produkten behöver inte klassificeras. Testdata finns ej tillgängligt.
Hud, anfrätning/irritation: Kan vara hudirriterande - kan orsaka rodnad. Produkten behöver inte klassificeras. Testdata finns ej tillgängligt.
Allvarlig ögonskada/ögonirritation:Kontakt med ögonen kan orsaka svåra frätskador, smärta, tårbildning och kramper i ögonlock. Risk för allvarliga ögonskador/synskador.
Luftvägssensibilisering eller hudsensibilisering:
Mutagenitet i könsceller:
Cancerframkallande:
Produkten behöver inte klassificeras. Testdata finns ej tillgängligt.
Produkten behöver inte klassificeras. Testdata finns ej tillgängligt.
Produkten behöver inte klassificeras. Testdata finns ej tillgängligt.
Reproduktionstoxicitet: Produkten behöver inte klassificeras. Testdata finns ej tillgängligt.
Enstaka STOT-exponering:Inandning av spraydimma kan orsaka irritation i de övre luftvägarna. Produkten behöver inte klassificeras. Testdata finns ej tillgängligt.
Upprepad STOT-exponering:Produkten behöver inte klassificeras. Testdata finns ej tillgängligt.
Fara vid aspiration:
Produkten behöver inte klassificeras. Testdata finns ej tillgängligt.
Annan giftig inverkan: Inga kända.
AVSNITT 12: Ekologisk information
12.1 Toxicitet
12.2 Persistens och nedbrytbarhet
Produkten behöver inte klassificeras. Testdata finns ej tillgängligt.
Testdata finns ej tillgängligt.
12.3 Bioackumuleringsförmåga
12.4 Rörligheten i jord
Förväntas inte att lagras i biomassa.
7722-84-1: Fördelningskoefficient n-oktanol/vatten: -1,57
Testdata finns ej tillgängligt.
12.5 Resultat av PBT- och vPvB-bedömningen
12.6 Andra skadliga effekter
Ingen bedömning har gjorts.
Inga kända.
AVSNITT 13: Avfallshantering
13.1 Avfallsbehandlingsmetoder
Undvik utsläpp i avloppssystem eller till ytvatten. Samla upp spill och avfall i slutna läckagesäkra behållare för deponering vid lokal uppsamlingsplats för farligt avfall.
EWC-kod: Beror på verksamhetsområde och användning, t.ex. 16 09 03 Peroxider, t.ex. väteperoxid
Absorptionsmedel/trasor förorenat av produkten:
EWC-kod: 15 02 02 Absorbermedel, filtermaterial (även oljefilter som inte anges på annan plats), torkdukar och skyddskläder förorenade av farliga ämnen. Icke rengjord förpackning ska sopsorteras enligt lokala avfallsbestämmelser.
AVSNITT 14: Transport information
ADR/RID
14.1 UN-nummer 2984
14.2 Officiell transportbenämningVÄTEPEROXID, VATTENLÖSNING
14.3 Faroklass för transport5.1
14.4 Förpackningsgrupp III
Farlighetsnummer 50
Tunnelrestriktionskod E
14.5 Miljöfaror Produkten skall inte märkas som miljöfarlig (symbol: fisk och träd).
ADN
14.1 UN-nummer 2984
14.2 Officiell transportbenämningHYDROGEN PEROXIDE, AQUEOUS SOLUTION
14.3 Faroklass för transport5.1
14.4 Förpackningsgrupp III
14.5 Miljöfaror Produkten skall inte märkas som miljöfarlig (symbol: fisk och träd).
Miljörisk i tankfartyg: Ej tillämpligt.
IMDG
14.1 UN-nummer 2984
14.2 Officiell transportbenämningHYDROGEN PEROXIDE, AQUEOUS SOLUTION
14.3 Faroklass för transport5.1
14.4 Förpackningsgrupp III
14.5 Miljöfaror Produkten är inte Marine Pollutant (MP)
IMDG-kod segregationsgrupp:-
ICAO/IATA
14.1 UN-nummer
14.2 Officiell transportbenämningHYDROGEN PEROXIDE, AQUEOUS SOLUTION
14.3 Faroklass för transport5.1
14.4 Förpackningsgrupp III
14.6 Särskilda försiktighetsåtgärder Inga.
14.7 Bulktransport enligt bilaga II till MARPOL 73/78 och IBC-koden Ej tillämpligt.
AVSNITT 15: Gällande föreskrifter
15.1 Föreskrifter/lagstiftning om ämnet eller blandningen när det gäller säkerhet, hälsa och miljö
Specialbestämmelser:
15.2 Kemikaliesäkerhetsbedömning
Kemikaliesäkerhetsvärdering har inte utförts.
AVSNITT 16: Annan information Förklaring av förkortningar: PBT: Persistent, Bioaccumulative and Toxic vPvB: Very Persistent and Very Bioaccumulative STOT: Specific Target Organ Toxicity
Klassificeringsmetod:
R-fraser:
H-fraser:
R10 Brandfarligt.
R20/22 Farligt vid inandning och förtäring.
R22 Farligt vid förtäring.
R35 Starkt frätande.
R41 Risk för allvarliga ögonskador.
R5 Explosivt vid uppvärmning.
R8 Kontakt med brännbart material kan orsaka brand.
H226 Brandfarlig vätska och ånga.
H271 Kan orsaka brand eller explosion. Starkt oxiderande.
H302 Skadligt vid förtäring.
H314 Orsakar allvarliga frätskador på hud och ögon.
H318 Orsakar allvarliga ögonskador.
H332 Skadligt vid inandning.
Utbildning: En förutsättning är att ha grundliga kunskaper om detta säkerhetsdatablad.